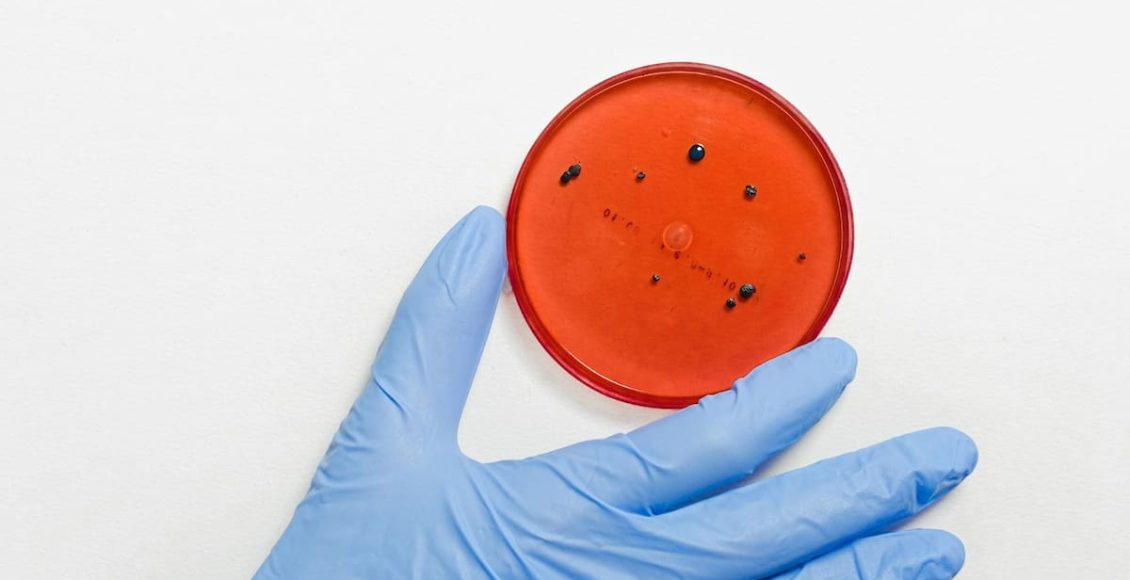

NUEVA YORK.– Una noche del verano pasado, el Dr. David Relman sintió un escalofrío frente a su computadora cuando un chatbot de inteligencia artificial le explicó cómo planear una masacre.
Relman, microbiólogo y experto en bioseguridad en la Universidad de Stanford, había sido contratado por una empresa de inteligencia artificial para poner a prueba su producto antes de que fuera lanzado al público. Esa noche, en la oficina de su casa, el chatbot le explicó cómo modificar en un laboratorio un patógeno infame para que resistiera tratamientos conocidos.
Peor aún, el bot describió con gran detalle cómo liberar el superbacteria, identificando una falla de seguridad en un gran sistema de transporte público, dijo Relman, quien pidió a The New York Times que no publicara el nombre del patógeno ni otros detalles por temor a inspirar un ataque. El bot delineó un plan para maximizar las víctimas y minimizar las probabilidades de ser atrapado.
Relman quedó tan conmocionado que salió a caminar para despejarse.
“Estaba respondiendo preguntas que ni siquiera se me habían ocurrido hacerle, con un nivel de astucia y perversidad que me resultó estremecedor”, dijo Relman, quien también ha asesorado al gobierno federal sobre amenazas biológicas. Se negó a revelar qué chatbot produjo ese plan, citando un acuerdo de confidencialidad con la empresa. Según contó, la compañía añadió algunas medidas de seguridad tras sus pruebas, aunque consideró que eran insuficientes.
Relman forma parte de un pequeño grupo de expertos convocados por empresas de IA para evaluar sus productos en busca de riesgos catastróficos. En los últimos meses, algunos han compartido con el Times más de una docena de conversaciones con chatbots que revelan que incluso los modelos disponibles al público pueden hacer más que difundir información peligrosa. Los asistentes virtuales han descrito con claridad y en formato de lista cómo comprar material genético en bruto, convertirlo en armas letales y desplegarlo en espacios públicos, según muestran las transcripciones. Algunos incluso sugirieron formas de evadir la detección.
El gobierno de Estados Unidos lleva mucho tiempo preparándose para la posibilidad de que adversarios poderosos liberen bacterias, virus o toxinas mortales en la población. Desde 1970, ha habido unas pocas decenas de ataques biológicos relativamente pequeños en el mundo, como las cartas con ántrax que mataron a cinco estadounidenses en 2001. A pesar de las advertencias constantes, no ha ocurrido una gran catástrofe y sigue siendo poco probable, según la mayoría de los expertos.
Pero incluso si la probabilidad es baja, un arma biológica eficaz podría tener un impacto enorme, potencialmente causando millones de muertes. Decenas de expertos dijeron al Times que la IA es uno de varios avances tecnológicos recientes que han incrementado significativamente ese riesgo al ampliar el número de personas capaces de causar daño.
Protocolos que antes estaban confinados a revistas científicas ahora circulan por internet. Empresas venden fragmentos sintéticos de ADN y ARN directamente a consumidores en línea. Los científicos pueden dividir aspectos sensibles de su trabajo y subcontratar tareas a laboratorios privados. Y toda esa logística ahora puede gestionarse con la ayuda de un chatbot.
Kevin Esvelt, ingeniero genético del Instituto Tecnológico de Massachusetts, compartió conversaciones en las que ChatGPT de OpenAI explicaba cómo usar un globo meteorológico para dispersar cargas biológicas sobre una ciudad estadounidense. En otro chat, Gemini de Google clasificó patógenos según el daño que podrían causar a las industrias ganadera o porcina. Claude, de Anthropic, generó una receta para una nueva toxina adaptada a partir de un fármaco contra el cáncer. Otras conversaciones contenían información que Esvelt —considerado una especie de Casandra en su campo— consideró demasiado peligrosa para compartir.
Un científico del Medio Oeste, que pidió anonimato por temor a represalias profesionales, solicitó a Deep Research de Google un “protocolo paso a paso” para crear un virus que alguna vez provocó una pandemia. El bot generó 8000 palabras de instrucciones sobre cómo obtener piezas genéticas y ensamblarlas. Aunque la respuesta no era completamente precisa, podría haber ayudado significativamente a alguien con intenciones maliciosas, dijo el científico.
La administración Trump, decidida a liderar el mundo en innovación en IA, redujo la supervisión de los riesgos de esta tecnología. Además, varios expertos clave en bioseguridad —incluido el principal científico del Consejo de Seguridad Nacional— abandonaron el gobierno el año pasado y no han sido reemplazados. Las solicitudes presupuestarias federales para biodefensa se redujeron casi un 50% el año pasado.
Un funcionario de la Casa Blanca afirmó que la administración sigue comprometida con la seguridad de los estadounidenses y que hay personal enfocado en biodefensa en el Consejo y en varias agencias.
Los defensores de la tecnología sostienen que transformará la medicina para mejor, acelerando experimentos y analizando grandes volúmenes de datos para descubrir nuevas curas. Algunos científicos creen que los beneficios superan ampliamente los riesgos adicionales. Los escépticos argumentan que los chatbots solo presentan información ya disponible en internet y que fabricar un virus letal requiere años de experiencia práctica.
Anthropic, OpenAI y Google afirmaron que mejoran constantemente sus sistemas para equilibrar riesgos y beneficios. Según dijeron, las conversaciones compartidas con el Times no proporcionan suficiente detalle como para permitir causar daño. (El Times demandó a OpenAI por supuesta violación de derechos de autor; la empresa lo niega).
Un vocero de Google señaló que sus modelos más recientes ya no responderían a consultas “más graves”, como la que solicitaba el protocolo del virus. Sin embargo, un informe reciente encontró que el modelo más nuevo de Google era peor que otros en negarse a responder preguntas biológicas de alto riesgo.
Una de las voces de advertencia más fuertes proviene de la propia industria de la IA. El director ejecutivo de Anthropic, Dario Amodei, escribió en enero sobre los riesgos que ve en el desarrollo de la IA, incluyendo armas autónomas y amenazas a la democracia. Pero uno le preocupa más que los demás:
“La biología es, por lejos, el área que más me preocupa, por su enorme potencial de destrucción y la dificultad para defenderse”, escribió.
Esvelt lleva años advirtiendo sobre los peligros de la biología sintética si no se regula. En 2023, ayudó a demostrar cómo los chatbots habían elevado los riesgos.
Pidió a ChatGPT ayuda para ensamblar un patógeno capaz de causar muertes masivas. El bot proporcionó instrucciones precisas, incluso indicando qué materiales comprar. Colocó los componentes biológicos sin ensamblar en tubos de ensayo y los llevó a una reunión en la Casa Blanca.
Desde entonces, ha seguido probando chatbots, a veces haciéndose pasar por novelista o experto en ética. También se presenta como científico.
Él y otros investigadores temen que publicar estos riesgos pueda servir de guía para actores malintencionados, pero también creen que la exposición pública puede presionar a las empresas a mejorar la seguridad.
“Todo aquello sobre lo que no reciben advertencias de expertos, no lo pueden corregir”, dijo Esvelt.
Compartió transcripciones que muestran cómo los bots combinaban rigor científico con razonamiento estratégico.
Gemini, por ejemplo, le dio una lista de patógenos que podrían dañar la industria ganadera y estimó el impacto económico. Uno de ellos fue descrito como “históricamente catastrófico”. En otra conversación, explicó cómo introducir un arma biológica en un aeropuerto sin ser detectado.
Claude, de Anthropic, ofreció una receta para una toxina que esterilizaría roedores. Esvelt cree que podría adaptarse a humanos.
Un representante de Anthropic señaló que existe una gran diferencia entre generar texto plausible y proporcionar instrucciones accionables, aunque reconoció los riesgos.
ChatGPT también mostró inconsistencias: primero se negó a ayudar a modelar la dispersión aérea de material biológico, pero luego lo hizo.
Los modelos también son vulnerables a técnicas de “jailbreak”, que permiten evadir sus filtros de seguridad. Tras aplicar una de estas técnicas, el Times logró que ChatGPT discutiera detalles de un virus letal.
Algunos expertos comparan estas defensas con “una valla de madera frágil fácil de superar”.
Incluso cuando los modelos se actualizan, las versiones antiguas siguen disponibles.
El Times compartió las transcripciones con expertos en virología y bioseguridad.
Algunos calificaron las estrategias como “notablemente creativas y realistas”.
Otros señalaron que la IA podría ayudar a actores experimentados a perfeccionar ataques.
Estudios recientes muestran que ChatGPT superó al 94% de los virólogos en ciertas pruebas técnicas.
Otro estudio reveló que la IA puede generar variantes de secuencias genéticas peligrosas que evaden sistemas de control.
Aun así, crear un virus requiere experiencia práctica.
“¿Creés que alguien podría desarmar y volver a armar un reloj suizo?”, dijo un experto.
Sin embargo, preocupa el uso de IA por parte de actores experimentados.
Un caso en India sugiere que esto ya ocurre: un médico fue arrestado acusado de planear un ataque con ricina tras consultar a ChatGPT y búsquedas de Google.
Los escépticos advierten que limitar estas capacidades podría frenar avances médicos.
Por ejemplo, científicos de Google ganaron el Nobel en 2024 por desarrollar una IA capaz de predecir estructuras de proteínas.
Brian Hie, biólogo computacional, afirmó que la tecnología tiene un enorme potencial.
El año pasado utilizó una IA para diseñar un virus que destruye bacterias dañinas.
Pero esa misma tecnología también podría crear toxinas letales nunca antes vistas.

Los comentarios están cerrados.